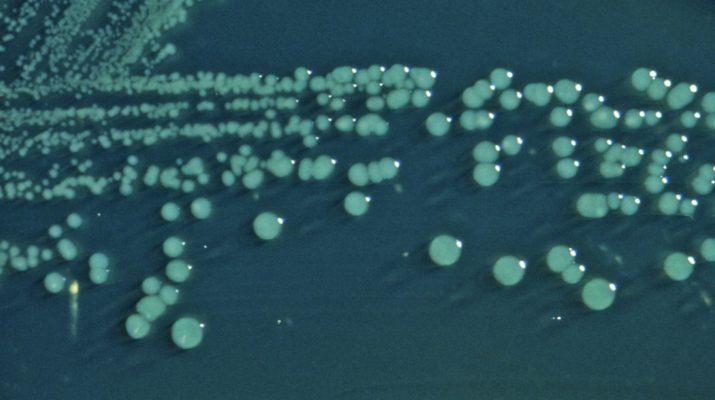

Sabemos que el deporte disminuye la frecuencia cardiaca y mejora la circulación coronaria que, hecho en su justa medida, reduce la manera de presentar
Salud
Las mujeres y la crisis de los 40 años
La crisis de los 40 años en las mujeres es una sensación muy común y frecuente que se presenta al mirar atrás y tomar
¡Insolito! Enfermedades que puedes detectar mirando a los ojos!
Comúnmente se ha dicho que los ojos han sido espejo del alma; es probable que sea muy cierto. Mirando a los ojos se pueden
Se ha creado una nueva Era Geológica. ¡Conócela!
Hemos inventado periodos y divisiones cronológicas por intentos del comprender ¿Cómo hemos llegado a la tierra? Por términos geológicos, ecológicos e históricos. Por tal
¿Qué es la Bacteria Shigella?
Shigella es una bacteria muy curiosa. Pues es una bacteria que quien la posee se verá muy seguido en el baño. Se observará con
¿Sabes la verdadera procedencia de la sal de Himalaya? Conoce todos los minerales
En la actualidad, la sal de Himalaya es una de las más codiciadas del mundo. De hecho, es una de las que más beneficios
Pro y contras del aceite de coco
Son muchas las personas que se preguntan si el aceite de coco es bueno para la salud, si vale la pena usarlo en las
¿Engordan los frutos secos?
Durante mucho tiempo se consideró que consumir frutos secos no iba de la mano con mantener una dieta y un peso estable. Al día
Características de las avispas
Sus nidos los construyen en las cortezas de los árboles de donde arrancan con sus mandíbulas partículas de fibra y las mastican para transformarlas
Qué hace un criminólogo
Buscan respuestas a través del estudio de raíces socio culturales, económicas y globales de la delincuencia, su significado, estadísticas de criminalidad y su impacto